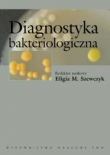

Witaj niezarejestrowany
Przechowalnia
Tylko zalogowani klienci sklepu mogą korzystać z przechowalni
Diagnostyka bakteriologiczna
Kategorie: Biologia komórki. Cytologia. Mikrobiologia. Wirusologia
, Diagnostyka medyczna
, Choroby zakaźne. Epidemiologia. Pasożytnicze i odzwierzęce
, Szkoły policealne. Szkoły wyższe
Isbn: 8301144734
Ean: 978830114473901
Liczba stron: 364
Format: 16.0x23.0cm
W książce przedstawiono diagnostykę bakteriologiczną w dwóch aspektach:
1. szeroki przegląd bakterii związanych z człowiekiem
podstawy taksonomii bakterii, aktualna systematyka, dane dotyczące źródeł i rezerwuarów bakterii, najważniejsze cechy patogenezy i przebiegu zakażeń, rodzaje materiału klinicznego w diagnostyce chorób, szczegółowa charakterystyka tych cech ekologii, morfologii i metabolizmu bakterii, które mogą być wykorzystane w diagnostyce, a także tradycyjne i najnowsze metody identyfikacyjne (biologia molekularna);
2. postępowanie diagnostyczne
przegląd materiałów klinicznych, sposoby ich pobierania, przechowywania i transportu, najkorzystniejsze metody identyfikacyjne i diagnostyczne, praktyczne schematy postępowania w badaniu materiałów klinicznych.
Polecamy studentom, pracownikom laboratoriów mikrobiologicznych, stacji sanitarno-epidemiologicznych oraz lekarzom wszystkich specjalności, a zwłaszcza specjalizującym się w mikrobiologii.
Oprawa: kartonowa
Wydawca: PWN Wydawnictwo Naukowe
Brak na magazynie
Inne produkty tego wydawcy:
Informacje
Dane kontaktowe
| Księgarnia internetowa "booknet.net.pl" ul.Kaliska 12 98-300 Wieluń |
Godziny otwarcia: pon-pt: 9.00-17.00 w soboty 9.00-13.00 |
Dane kontaktowe: e-mail: info@booknet.net.pl e-mail: info@booknet.net.pl
|

© copyright by BOOKNET